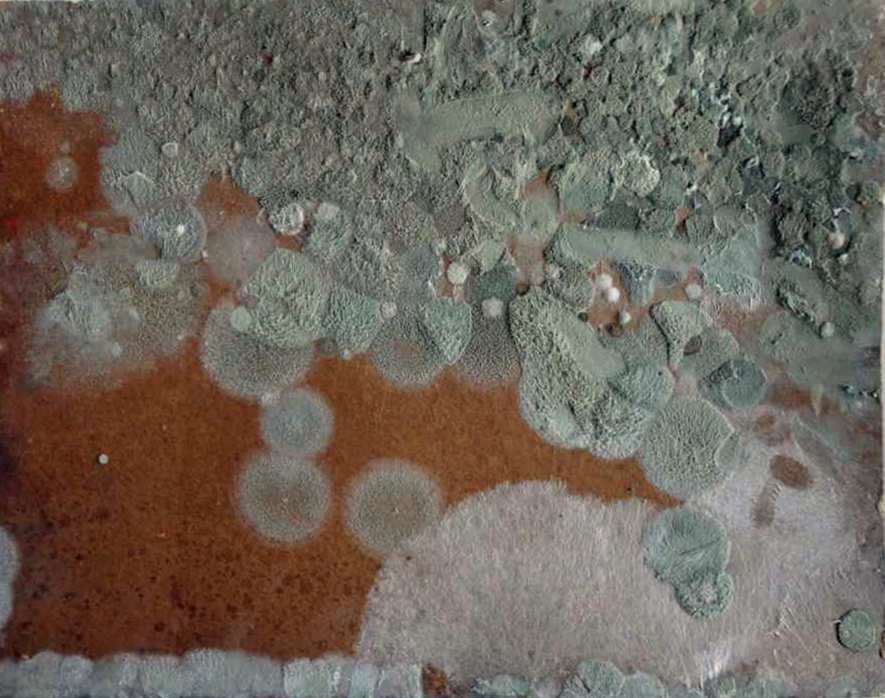

Moisissures :
:

Ecaillages et manquesDégâts des eauxAllègements - nettoyagesCraquelures prématuréesPoussières, scrupules entre la toile et le châssisDéchiruresLacunes de support et de couche coloréeGriffuresRetouche et mastic abusifsMoisissuresAnciennes restaurations pièces et repeintsBoursouflures - cloquesHistorique du tableau inscriptions et étiquettes à conserver